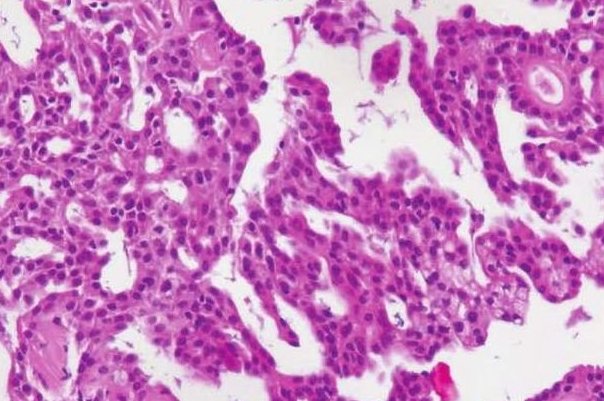
异型性的名词解释

异型性是指细胞或物体在形状、大小、相对位置、内部结构等方面与正常状态或标准模式不一致的现象。
在生物学和医学领域,异型性是一个非常重要的概念,它与细胞的分化、发育、肿瘤发生和器官形成等过程密切相关。在生物学中,异型性是指同一组织或器官中的细胞在形态、大小、内部结构等方面存在差异的现象。
这种差异通常是由于细胞分化的不同阶段或不同类型细胞之间的差异所导致的。例如,在人体发育过程中,不同类型的细胞会逐渐分化成具有特定形态和功能的细胞,如肌肉细胞、神经细胞、皮肤细胞等。

这些细胞在形态、大小、内部结构等方面都存在明显的差异,这是由于它们在不同的发育阶段和不同的分化状态下具有不同的基因表达和蛋白质合成所导致的。
在医学中,异型性通常与肿瘤的发生和发展密切相关。肿瘤细胞通常具有与正常细胞不同的形态和内部结构,这些差异被称为异型性。异型性是判断肿瘤良恶性的重要指标之一,通常被认为是肿瘤恶性程度的标志之一。一般来说,恶性肿瘤的异型性较大,良性肿瘤的异型性较小。
除了肿瘤之外,异型性还与器官形成和发育密切相关
在胚胎发育过程中,不同类型的细胞会逐渐分化成具有特定形态和功能的器官和组织,如心脏、肝脏、肾脏等。这些器官和组织的形成过程中也存在明显的异型性,这是由于不同类型细胞之间的相互作用和基因表达的不同所导致的。
总之,异型性是一个广泛存在于生物学和医学领域中的概念,它与细胞的分化、发育、肿瘤发生和器官形成等过程密切相关。了解和理解异型性的基本原理和机制对于我们更好地理解生命现象和疾病发生发展具有重要意义。
